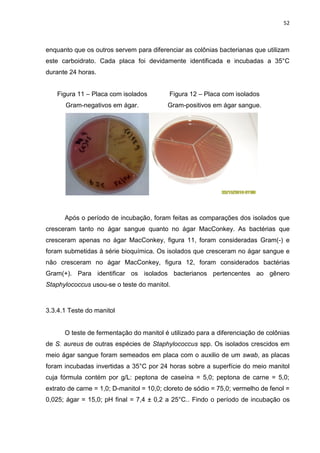
52



enquanto que os outros servem para diferenciar as colônias bacterianas que utilizam
este carboidrato. Cada placa foi devidamente identificada e incubadas a 35°C
durante 24 horas.


    Figura 11 – Placa com isolados         Figura 12 – Placa com isolados
       Gram-negativos em ágar.             Gram-positivos em ágar sangue.
             .MacConkey.




      Após o período de incubação, foram feitas as comparações dos isolados que
cresceram tanto no ágar sangue quanto no ágar MacConkey. As bactérias que
cresceram apenas no ágar MacConkey, figura 11, foram consideradas Gram(-) e
foram submetidas à série bioquímica. Os isolados que cresceram no ágar sangue e
não cresceram no ágar MacConkey, figura 12, foram considerados bactérias
Gram(+). Para identificar os isolados bacterianos pertencentes ao gênero
Staphylococcus usou-se o teste do manitol.



3.3.4.1 Teste do manitol


      O teste de fermentação do manitol é utilizado para a diferenciação de colônias
de S. aureus de outras espécies de Staphylococcus spp. Os isolados crescidos em
meio ágar sangue foram semeados em placa com o auxilio de um swab, as placas
foram incubadas invertidas a 35°C por 24 horas sobre a superfície do meio manitol
cuja fórmula contém por g/L: peptona de caseína = 5,0; peptona de carne = 5,0;
extrato de carne = 1,0; D-manitol = 10,0; cloreto de sódio = 75,0; vermelho de fenol =
0,025; ágar = 15,0; pH final = 7,4 ± 0,2 a 25°C.. Findo o período de incubação os

Este documento apresenta os resultados de um estudo sobre a qualidade da água consumida por alunos de 20 escolas estaduais em Boa Vista, RR. Amostras de água foram testadas para a presença de coliformes e bactérias heterotróficas, e bactérias isoladas foram identificadas e testadas para resistência a antibióticos. Alguns resultados indicaram contaminação da água, e muitas bactérias isoladas mostraram resistência a vários antibióticos comumente usados.

![85
BARRETO, E. F. Análise microbiológica da água fornecida a unidades de
alimentação de regiões administrativas do Distrito Federal-DF. Anuário da
Produção de Iniciação Científica Discente, Valinhos, v. 12, n. 13, p. 7-15. 2009.
BAUER, A; PERRY, D; KIRBY, W. Drug usage and antibiotic susceptibility of
staphylococci. Journal of the American Medical Association, Chicago, v. 4,
n.173, p. 475-480, jun. 1960.
BENVINISTE, R; DAVIES, J. Mechanisms of antibiotic resistance in bacteria. Annus
Review of Biochemmistry, Palo Alto, v. 42, p. 471-506, jul. 1973.
BOMFIM, M. V. J. et al. Avaliação físicoquímica e microbiológica da água de
abastecimento do laboratório de bromatologia da UERJ. Revista Higiene
Alimentar, São Paulo, v. 21, n. 152, p. 99-103, jun. 2007.
BRADFORD, P. A. Extended-spectrum beta-lactamases in the 21st century:
characterization, epidemiology, ande detection of this important resistance threat.
Clinical Microbiology Reviews, Washington, v. 14, n. 4, p. 933-951, out. 2001.
BRASIL. Lei nº 7.347, de 24 de julho de 1985, Lei das águas. Disponível:
http://www.rededasaguas.org.br/legisl. Acesso em: 10 de mar. de 2010.
BRASIL. Ministério da Saúde. Portaria n° 518, de 25 de março de 2004. Aprova a
norma de qualidade da água para consumo humano. Disponível em:
http://dtr2001.saude.gov.br/sas/PORTARIAS/Port2004/GM/GM-518.htm. Acesso em
11 fev. 2010.
BRASIL. Ministério da Saúde. Inspeção sanitária em abastecimento de água.
Brasília: Ministério da Saúde, 2006. 84p.
BROOKS, G. F. et al. Jawetz, Melnick e Adelberg: Microbiologia Médica. 20. ed.
Rio de Janeiro: McGraw-Hill Interamericana do Brasil, 2009. 820p.
BÜCHELE, D. S.; RIZZARDI, A.; AMARAL, C. H. Avaliação da qualidade da água de
escolas do interior do município de Cruz Alta - RS. In: SEMINÁRIO
INTERINSTITUCIONAL DE ENSINO, PESQUISA E EXTENSÃO. 15, 2010, Cruz
Alta. Anais... [s.l.]: Disponível em:
http://www.unicruz.edu.br/15_seminario/seminario.pdf. Acesso em: 07 jun. 2011.](https://image.slidesharecdn.com/10632395-111218192451-phpapp02/85/IlzoCostaPessoa-88-320.jpg)
![86
BUU-HOI, A.; GOLDSTEIN, F.W.; ACAR, J. F. R-factors in Gram-positive and Gram-
negative aerobic bacteria selected by antimicrobial therapy. Scandinavian Journal
of Infectious Diseases, Bethesda, v. 49, p. 46-55, jan.1986.
CAER. Companhia de água e esgoto de Roraima. 2011. Disponível em:
http://www.caer.com.br/. Acesso em: 14 jun. 2011.
CALAZANS, G. M. T. et al. Análises bacteriológicas de águas provenientes de
creches, asilos e poços artesianos situados próximos ao campus da UFPE. In:
CONGRESSO BRASILEIRO DE EXTENSÃO UNIVERSITÁRIA, 2, 2004, Belo
Horizonte. Anais... [s.l.]: Disponível em: http://www.ufmg.br.pdf Acesso em: 25 jul.
2011.
CARVALHO, D. R. et al. Avaliação da qualidade físico-química e microbiológica da
água de um Campus Universitário de Ipatinga-MG. Nutrir Gerais, Ipatinga, v. 3, n. 5,
p. 417-427, ago./dez. 2009.
CEARÁ – Superintendência Estadual do Meio Ambiente. Cartilha de água.
Fortaleza: SEMACE, 2004. 20p.
CETESB. Norma técnica L 220: Pseudomonas aeruginosa – Determinação em
amostras de água técnica de membrana filtrante. São Paulo: CETESB, 1993. 30p.
CETESB. Norma técnica L 5.202: Coliformes totais e fecais – Determinação do
número mais provável pela técnica de tubos múltiplos. São Paulo: CETESB, 1998.
39p.
CETINKAYA, Y; FALK, P; MAYHALL, C. G. Vancomycin-resistant enterococci.
Clinical Microbiology Reviews, Washington, v. 13, n. 4, p. 686-707, out. 2000.
CHAMBERS, H. F. Methicillin resistance in staphylococci: molecular and biochemical
basis and clinical implications. Clinical Microbiology Reviews, Washington, v. 10,
n.4, p. 781-791, out. 1997.
CHARACKLIS, W. G.; WILDERER, P. A. Structure and function of biofilms. John
Wiley & Sons, Chichester. 1989.
CHAVES, L. C. D. Estudo da cinética de formação de biofilmes em superfícies
em contacto com água potável. 2004. 186p. Dissertação (Mestrado em Tecnologia
do Ambiente) – Universidade de Minho, 2004.](https://image.slidesharecdn.com/10632395-111218192451-phpapp02/85/IlzoCostaPessoa-89-320.jpg)



![90
KURYLOWICZ, W. Antibióticos - Uma revisão crítica. Recife: Editora Universitária
– Universidade Federal de Pernambuco, 1981. 341p.
LAGE, M. M.; BADARÓ, A. C. L.; BARBOSA, D. A. Monitoramento da qualidade
microbiológica da água dos bebedouros do Campus Amaro Lanari Jr. In: SEMANA
DE INICIAÇÃO CIENTÍFICA, 9, 2008, Coronel Fabriciano. Anais... [s.l.]: Disponível
em: http://www.unilestemg.br/pic/sic_09/resumos/saude.pdf. Acesso em: 07 jun.
2011.
LECHEVALLIER, M. W.; MCFETERS, G. A. Interactions between Heterotrophic
Plate Count Bacteria and Coliform Organisms. Applied and Environmental
Microbiology, Washington, v. 49, p. 1338-1341, maio. 1985.
LEITÃO, M. F. F. et al. Tratado de Microbiologia. São Paulo: Manole, 1988. 186p.
LEUNG, T; WILLIAMS, J. D. Beta-lactamases of subspecies of bacteroides fragilis.
Journal Antimicrobial Chemotherapy, Ottawa, v. 4, n. 8, p. 47-54, jul. 1978.
LI, W. M. K.; LACROIX, B.; POWELL, D. A. The microbiological safety of bottled
water in Canada. 2001. Disponível em: http://foodsafety.k-
state.edu/articles/468/micro_sfty_bottled_water_canada.pdf. Acesso em: 11 mar.
2010.
LIM, S. M; WEBB, S. A. Nosocomial bacterial infections in intensive Care Units. I:
Organisms and mechanisms of antibiotic resistance. Anaesthesia, Bethesda, v. 60,
n. 9, p. 887-902, set. 2005.
LINTON, A. H. Antibiotic-resistant bacteria in animal husbandry. British Medical
Bulletin, Oxford, v. 40, n. 1, p. 91-95, jan. 1984.
LIVERMORE, D, M. Of Pseudomonas, porins, pumps and carbapenems. Journal
Antimicrobial Chemotherapy, Ottawa, v. 47, n. 3, p. 247-250, mar. 2001.
MACÊDO, J. A. B. Águas & Águas. Juiz de Fora – MG: Ortofarma, 2001. 504p.
MACHADO, C. L. Avaliação da presence de microrganismos indicadores de
contaminação e patogênicos em líquidos lixiviados do aterro sanitário de Belo
Horizonte. 2004. 140p. Dissertação (Mestrado em Saneamento, Meio Ambiente e
Recursos Hídricos) – Universidade Federal de Minas Gerais, Belo Horizonte, 2004.](https://image.slidesharecdn.com/10632395-111218192451-phpapp02/85/IlzoCostaPessoa-93-320.jpg)

![92
NORD, C.E. et al. Beta-lactamases in anaerobic bacteria. Scandinavian Journal
Infectious Diseases, Bethesda, v. 46, p. 57-63. 1985.
NORDMANN, P. Trends in beta-lactam resistance among Enterobacteriaceae.
Clinical Infectious Diseases, Bethesda, v. 27, p. 100-106, ago. 1998.
OPAL, S. M; COHEN, J. Clinical Gram-positive sepsis: does it fundamentally differ
from Gram-negative bacterial sepsis? Critical Care Medicine, Bethesda, v. 27, n. 8,
p. 1608-1616, ago. 1999.
ORGANIZACION MUNDIAL DE LA SALUD. Guias para a calidad Del águas
potable: recomendaciones. 2. ed. Genebra: OMS, v.1, 1995. 195p.
ORGANIZACION MUNDIAL DE LA SALUD. Gabinete regional para a saúde.
Desinfecção da água, 1996. 20p.
ORGANIZAÇÃO PAN-AMERICANA DE SAÚDE - OPAS. Água e Saúde. Disponível
em: http://www.opas.org.br/sistema/fotos/agua. Acesso em: 3 dez. 2009.
ORTOLAN, M. G. S.; CARDOSO, M. R. A. I.; AYUB, M. A. Z. Perfil microbiológico de
bactérias mesófilas do efluente do hospital das clínicas de Porto Alegre. In:
CONGRESSO INTERAMERICANO DE ENGENHARIA SANITÁRIA E AMBIENTAL,
27, 2000, Porto Alegre. Anais... [s.l.]: Disponível em:
http://sbmicrobiologia.org.br/PDF/cdsbm/listaresumos.htm. Acesso em: 20 mar.
2010.
PAPANDREOU, S. et al. Multiantibiotic resistance of Gram-negative bacteria isolated
from drinking water samples in southwest Greece. Journal of Chemotherapy,
Trespiano, v. 12, n. 4, p. 267-273, ago. 2000.
PATRICK, D. M. et al. Per capita antibiotic consumption: how does a North American
jurisdiction compare with Europe? Clinical Infectious Diseases, Bethesda, v. 1, n.
39, p. 11-7, jul. 2004.
PAVLOV. D. et al. Potentially pathogenic features of heterotrophic plate count
bacteria isolated from treated and untreated drinking water. International Journal of
Food Microbiology, Toronto, v. 92, n.3, p. 275-287, maio. 2004.](https://image.slidesharecdn.com/10632395-111218192451-phpapp02/85/IlzoCostaPessoa-95-320.jpg)
![93
PAYMENT. P. et al. A randomized trial to evaluate the risk of gastrointestinal disease
due to consumption of drinking water meeting current microbiological standards.
American Journal of Public Health, Washington, v. 81, n.6, p.703-708, jun. 1991.
PERITI, P; MAZZEI, T. New criteria for selecting the proper antimicrobial
chemotherapy for severe sepsis and septic shock. International Journal
Antimicrobial Agents, Ottawa, v. 12, n. 2, p. 97-105, jul. 1999.
PETIGNAT, C. et al. Exogenous source of Pseudomonas aeruginosa in a intensive
care unit patients: implementation of infection control and follow-up with molecular
typing. Infection Control Hospital Epidemiology, New Jersey, v. 27, n. 9, p. 953 -
957, set. 2006.
PEZENTE, A. W. Análise microbiológica, física e química da água dos
bebedouros e torneiras consumida na E. E. B. Timbé do Sul, localizada no
centro do município de Timbé do Sul - SC. Criciuma, 2009. 43p. Trabalho de
Conclusão de Curso (Graduação) - Universidade do Extremo Sul Catarinense –
UNESC. Disponível em: http://www.bib.unesc.net/biblioteca/sumario.pdf. Acesso
em: 07 jun. 2011.
PINTO, C. A. G. et al. Comportamento microbiológico das infecções comunitárias no
Hospital Municipal Odilon Behrens (HNOB) – jan/94 a dez/95. In: CONGRESSO
BRASILEIRO DE INFECTOLOGIA, n. 9, 1996, Recife. Resumo... Recife: [s.l.], p.
184.
PONGELUPPE, A. T. et al. Avaliação de coliformes totais, fecais em bebedouros
localizados em uma instituição de ensino de Guarulhos-SP. Revista Saúde – UnG,
Guarulhos, v. 3, n. 2, p. 5-9, jun. 2009.
POOLE, K. Efflux-mediated resistance to fluoroquinolones in Gram-negative
bacteria. Antimicrobial Agents Chemotherapy, Bethesda, v. 44, n. 9, p. 2233-
2241, set. 2000.
POOLE, K. Efflux-mediated resistance to fluoroquinolones in Gram-positive bacteria
and the mycobacteria. Antimicrobial Agents Chemotherapy, Bethesda, v. 44, n.
10, p. 2595-2599, out. 2000.
RABELLO, S. B; GODOY, C. V. C.; SANTOS, F. R. W. Presença de bactérias em
instrumentais e superfícies do ambiente clínico odontológico. Revista Brasileira de
Odontologia, Rio de Janeiro, v.58, n.3, p. 184-187, maio - jun. 2001.](https://image.slidesharecdn.com/10632395-111218192451-phpapp02/85/IlzoCostaPessoa-96-320.jpg)

![95
SHLAES, D. M. et al. Society for healthcare epidemiology of America and infectious
diseases society of America joint Committee on the Prevention of Antimicrobial
Resistance: guidelines for the prevention of antimicrobial resistance in hospital.
Clinical Infectious Diseases, Bethesda, v. 25, n. 3, p. 584-599, set. 1997.
SILVA JR., E. A. Manual de controle higiênico-sanitário em alimentos. 5. ed. São
Paulo: Varela, 2002.
SILVA, N.; JUNQUEIRA. V. C. A.; SILVEIRA, N. F. A. Manual de Métodos de
Análises Microbiológicas de Alimentos. São Paulo: Varela, 1997. 295p.
SINGH, G. S. Beta-lactams in the new millennium. Part-II: cephems, oxacephems,
penams and sulbactam. Mini Reviews in Medicinal Chemistry, Bethesda, v. 4, n. 1,
p. 93-109, jan. 2004.
SIQUEIRA, L. P. et al. Avaliação microbiológica da água de consumo empregada em
unidade de alimentação. Ciência & Saúde Coletiva, Manguinhos, v. 15, n. 1, p. 63 -
66, set. 2010.
SOARES, J. B.; MAIA, A. C. F. Água: Microbiologia e tratamento. Fortaleza: UFC,
1999. 206p.
SORUM, H.; ABÉE-LUND, T.M. Antibiotic resistance in food-related bacteria – a
result of interfering with the global web of bacterial genetics. International Journal
of Food Microbiology, Toronto, v. 78, n. 1, p. 43-56, set. 2002.
SOUZA, L.F. Composição de resíduos sólidos de serviços de saúde com
resíduos urbanos. 2003. 169p. Tese (Doutorado em Engenharia de Recursos
Hídricos e Saneamento Ambiental) - Instituto de Pesquisas Hidraúlicas,
Universidade Federal do Rio Grande do Sul, Porto Alegre, 2003.
SUASSUNA, I.; SUASSUNA, I. R. Perspectivas do emprego clínico dos antibióticos.
Tribuna Médica, [s.l.], v.14, n. 1, p.10-17, jan. 1971.
TANCREDI, R. C. P.; CERQUEIRA. E.; MARINS, B. R. Águas minerais
consumidas na cidade do Rio de Janeiro: avaliação da qualidade sanitária.
2002. Disponível em: http://www4.ensp.fiocruz.br/visa/publicacoes/_arquivos.pdf.
Acesso em: 11 mar. 2010.](https://image.slidesharecdn.com/10632395-111218192451-phpapp02/85/IlzoCostaPessoa-98-320.jpg)


